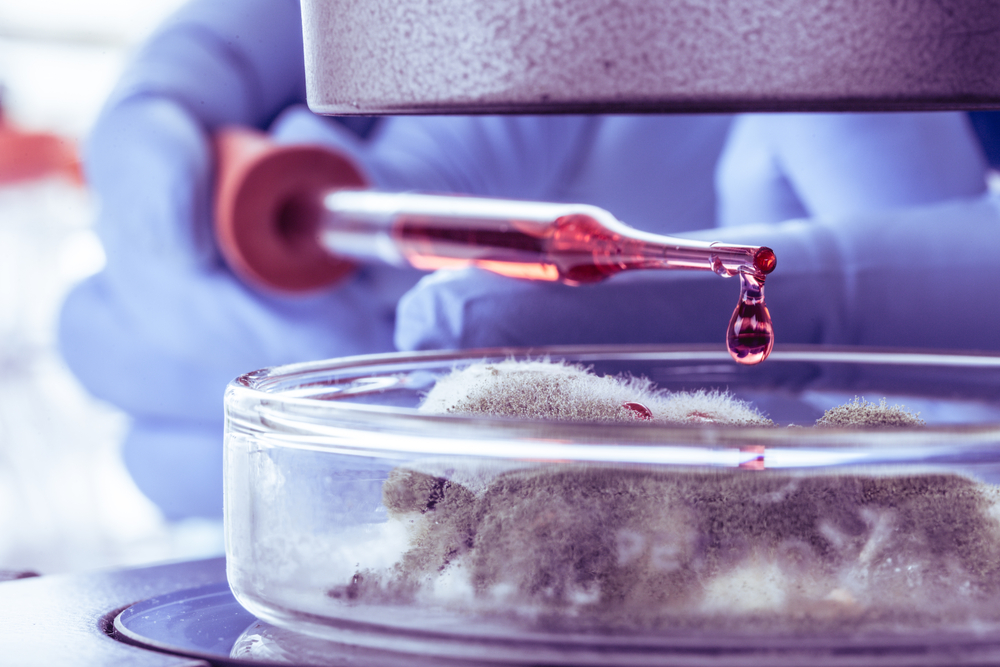

Produkty biobójcze odgrywają kluczową rolę w zapewnieniu higieny i bezpieczeństwa w wielu aspektach codziennego życia. Ich działanie jest niezbędne do walki z mikroorganizmami, które mogą stanowić zagrożenie dla życia i zdrowia ludzi i zwierząt. W zależności od rodzaju patogenu, z którym mają za zadanie sobie poradzić, produkty te można podzielić m.in. na bakteriobójcze, wirusobójcze i grzybobójcze. Każdy z tych typów charakteryzuje się specyficznymi właściwościami i mechanizmami działania, które są dostosowane do eliminowania określonych grup mikroorganizmów. W niniejszym artykule przyjrzymy się bliżej różnicom między tymi kategoriami produktów biobójczych, analizując ich skuteczność, zakres działania oraz potencjalne zastosowania.
Produkty biobójcze to substancje lub mieszaniny substancji przeznaczone do niszczenia, odstraszania, neutralizowania lub kontrolowania wszelkiego rodzaju szkodliwych organizmów przez działanie chemiczne lub biologiczne. W zależności od typu celowanego patogenu produkty te dzielą się m.in. na bakteriobójcze, wirusobójcze i grzybobójcze.
Bezpieczne stosowanie produktów biobójczych wymaga przestrzegania instrukcji producenta oraz odpowiednich regulacji prawnych. Należy pamiętać o potencjalnej toksyczności tych substancji dla ludzi i środowiska naturalnego przy niewłaściwym użyciu. Dlatego ich wybór i aplikacja muszą być przemyślane i oparte na aktualnej wiedzy naukowej.
Wybór odpowiedniego produktu biobójczego jest kluczowy dla skutecznej dezynfekcji i ochrony zdrowia. Przed zakupem należy zwrócić uwagę na spektrum działania środka, które powinno być dostosowane do rodzaju patogenów, z którymi mamy do czynienia. Produkty biobójcze mogą być skuteczne np. przeciwko bakteriom, wirusom, grzybom lub pierwotniakom, a ich efektywność wobec konkretnych mikroorganizmów jest określona w badaniach laboratoryjnych.
Rejestracja produktów biobójczych jest obowiązkowym procesem, który zapewnia, że środek został dokładnie przebadany i uznany za bezpieczny oraz skuteczny przez odpowiednie organy regulacyjne. Informacje o rejestracji można znaleźć na etykiecie produktu lub w publicznych rejestrach. Jest to ważny element do rozważenia, ponieważ potwierdza legalność i wiarygodność produktu. Jeśli potrzebujesz wsparcia w procesie rejestracyjnym, zgłoś się do firmy Polskie Produkty Biobójcze.
Kolejnym aspektem jest stężenie substancji aktywnej w produkcie biobójczym. Wyższe stężenie może być wymagane do zwalczania bardziej odpornych mikroorganizmów lub w sytuacjach o wysokim ryzyku zakażenia. Jednakże należy pamiętać, że nie zawsze większe stężenie oznacza lepszą efektywność – istotna jest również zdolność substancji do penetracji komórek patogenu oraz jej mechanizm działania.
Ważne jest także sprawdzenie czasu działania produktu biobójczego oraz jego wpływu na różne powierzchnie i materiały. Niektóre środki mogą być korozjogenne lub powodować uszkodzenia materiałów, dlatego wybierając produkt, warto konsultować się ze specjalistami lub dokładnie analizować dostępne informacje producenta.
Podczas wyboru odpowiedniego produktu biobójczego nie można pominąć kwestii bezpieczeństwa użytkowania. Środki te mogą zawierać substancje toksyczne dla ludzi i zwierząt domowych, dlatego należy dokładnie zapoznać się z instrukcją stosowania oraz środkami ostrożności. W przypadku miejsc publicznych czy szpitali konieczne może być stosowanie dodatkowych środków ochrony osobistej przez personel aplikujący produkty biobójcze.
Ostatecznie decyzja o wyborze konkretnego produktu biobójczego powinna opierać się na gruntownej analizie potrzeb oraz ryzyka związanego z obecnością określonych patogenów w danym środowisku. Umożliwi to osiągnięcie maksymalnej efektywności przy jednoczesnym zachowaniu bezpieczeństwa dla użytkowników i otoczenia.